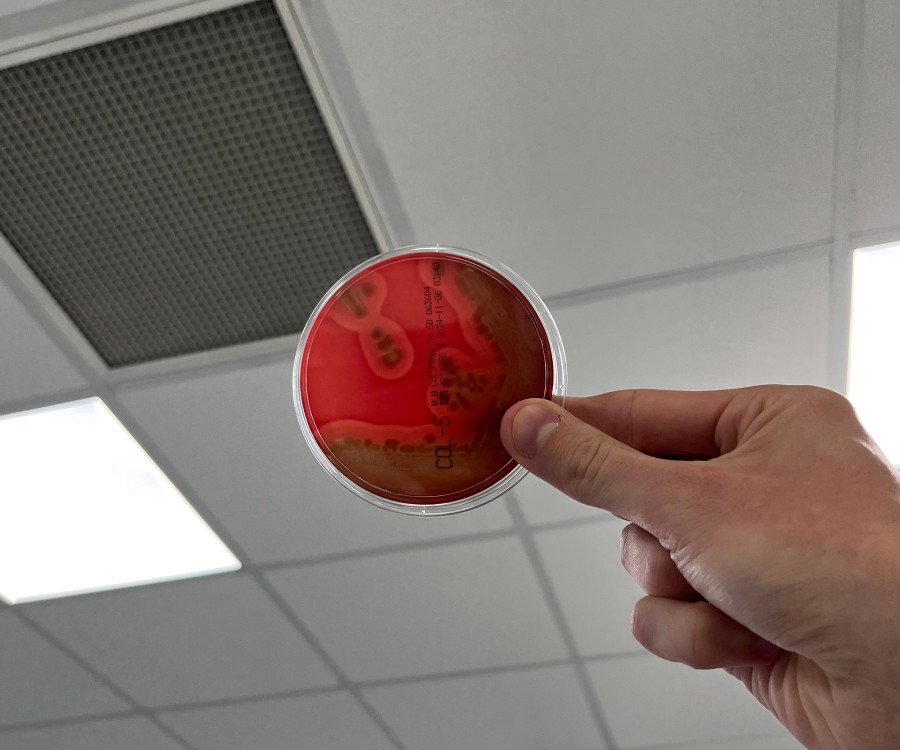
Image 2
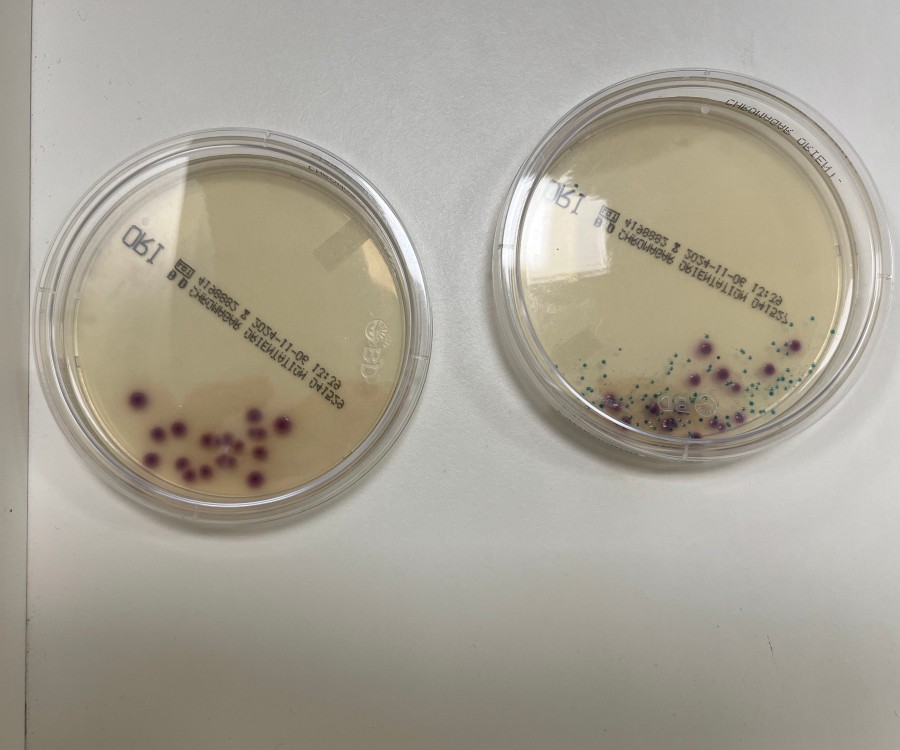
Image 8

Focus sur ...
Jour 1
Jour 2
Jour 3
Jour 4
Quelles sont les missions d'un biologiste médical ?
Portrait de Nicolas
Nicolas est biologiste médical et s’occupe d’un laboratoire où sont réalisées des analyses que ce soit pour dépister ou suivre des maladies. Son quotidien est partagé entre les salles de prélèvements, les plateaux techniques, son bureau et il veille à ce que ses équipes puissent travailler correctement.
Il est aussi autant en relation avec des médecins qu’avec des patients à qui ils donnent de plus amples explications si nécessaire.
N’hésite pas à regarder ces vidéos pour découvrir son quotidien !
« C’est un métier passionnant parce que c’est un métier au service des gens, de leur santé, mais aussi parce que ça suit les évolutions et innovations de la médecine. »
Le métier de biologiste médical
Le biologiste médical est un professionnel crucial dans le secteur de la santé. Responsable de l'exécution et de l'interprétation des analyses de prélèvements biologiques, il joue un rôle déterminant dans le diagnostic, la surveillance des traitements et la prévention des maladies. Exerçant principalement dans des laboratoires de biologie médicale, que ce soit en milieu hospitalier ou privé, il travaille souvent en collaboration avec une équipe composée de techniciens de laboratoire, d'autres biologistes et personnel médical. Sa fonction l'amène à combiner expertise technique et coordination d'équipe pour assurer la précision et la fiabilité des résultats.
Ses missions varient selon le poste et l’entreprise mais voici les principales :
Il réalise des analyses biologiques :
Il prélève ou supervise le prélèvement de spécimens biologiques comme le sang, l'urine ou des tissus.
Il réalise des tests et des analyses pour détecter des maladies, des virus ou des anomalies génétiques.
Il utilise des technologies de pointe pour examiner les échantillons et produire des résultats précis.
Il interprète les résultats :
Il évalue les résultats des analyses en comparaison avec les normes établies et le contexte clinique du patient.
Il rédige des rapports d'analyse détaillés qui seront utilisés par les médecins pour le diagnostic et le suivi des traitements.
Il communique ses conclusions au personnel médical, en fournissant des consultations et des recommandations basées sur les résultats obtenus.
Il supervise et forme le personnel de laboratoire :
Il gère une équipe de techniciens de laboratoire, en s’assurant de leur formation et de leur conformité aux protocoles de laboratoire.
Il veille au bon fonctionnement et à la maintenance des équipements utilisés.
Il met en place des standards de qualité et des protocoles pour assurer la sécurité et l'efficacité des procédures de laboratoire.
Il participe à la recherche et au développement :
Il conduit ou participe à des projets de recherche pour développer de nouvelles méthodes d'analyses ou améliorer les protocoles existants.
Il collabore avec d'autres chercheurs ou institutions pour contribuer à l'avancement des connaissances médicales.
Quelles sont les compétences d'un biologiste médical ?
Idéalement, un·e biologiste médical·e se montre :
passionné·e par le monde médical,
minutieux·se dans l’analyse et l'interprétation des résultats,
rigoureux·se dans le respect des protocoles de sécurité,
communicatif·ve et pédagogue avec les collègues et patients.
Au passage, réfléchis bien si (à prendre avec un peu d’humour) :
tu t’évanouis dès que tu vois une goutte de sang,
l’empathie c’est pas ton truc. Ici il faut accompagner les patients dans des moments difficiles,
tu perds tous tes moyens dès que tu stresses un peu,
l’organisation et toi, ça fait 2.
Avis Wilbi
Si tu ne te retrouves pas dans toutes ces qualités et ces compétences : c’est normal ! Laisse-toi le temps de les acquérir.
Comment devenir biologiste médical ?
Pour devenir biologiste médical, le DE (diplôme d'État) de docteur en pharmacie ou en médecine de niveau Bac+9 est nécessaire, suivi d'un DES (diplôme d'études spécialisées) en biologie médicale. Voici des exemples de parcours :
Niveau Bac pour accéder aux études supérieures
Bac général*
Avis Wilbi
*Les spécialités en lien peuvent être Mathématiques ; Sciences de la vie et de la terre ; Physique-chimie. Mais c’est à toi de voir en fonction de tes appétences et de ton projet ! Le choix d’enseignement de spécialité est un choix qui appartient à chaque personne, il se construit.
Pour démarrer les études supérieures :
PASS (Parcours d'Accès Spécifique Santé)
L.AS (Licence option Accès Santé)
Ensuite, il faut candidater à l’entrée aux études MMOP (médecine, maïeutique, odontologie, pharmacie). L’accès est sélectif avec des épreuves d’admission écrites et/ou orales.
Niveau Bac+6
Diplôme d'État de docteur en pharmacie
Diplôme d'État de docteur en médecine
Niveau Bac+9 et plus
DES (Diplôme d'Études Spécialisées) en biologie médicale
Certifications complémentaires
Certificat de capacité de prélèvement
Vaccinations spécifiques selon le Code de la santé publique
Avis Wilbi
Explorer les spécialisations lors du DES pour affiner les compétences.
Recrutement et emploi : où travaille un biologiste médical ?
Le métier de biologiste médical est principalement demandé dans les secteurs de la santé publique et privée. Les biologistes médicaux peuvent travailler dans des hôpitaux, des laboratoires d'analyses privés ou des centres de recherche.
Ils peuvent être salariés dans des institutions publiques ou privées, ou travailler à leur compte, notamment dans des structures privées.
Avis Wilbi
Réussir par une spécialisation pointue et pièces justificatives complètes.
Quel est le salaire d'un biologiste médical ?
Salaire débutant mensuel net :
un praticien hospitalier dans la fonction publique hospitalière : environ 3 300 €
un biologiste médical débutant à son compte dans un laboratoire privé : environ 4 300 €
Salaire moyen mensuel net : entre 4 000 € et 6 000 €
Ces chiffres sont là pour te donner une idée car les salaires varient selon l’expérience, l’entreprise, le statut, la spécialisation choisie, la zone géographique, etc.
Biologiste médical, quelles évolutions de carrière ?
Il peut évoluer vers des postes de chef de service dans les laboratoires hospitaliers, ou directeur de laboratoire en secteur privé.
Avis Wilbi
Echanger avec un professionnel est une bonne stratégie pour en savoir plus sur les possibilités d’évolution de carrière d’un métier.
Films, podcasts, livres...
Ici on compile quelques références pédagogiques ou divertissantes autour du métier et son univers. Attention, prise du recul nécessaire (notamment sur les films et séries) car ce n’est pas toujours le reflet de la réalité voire stéréotypé… Enjoy !
Série :
Biohackers (2020)
Documentaire :
Vive les microbes ! (2024), de Marie-Monique Robin
Podcast :
Côté Labo
Réseaux sociaux :
mon.biologiste (Instagram et TikTok)
Site :
www.lapbm.org
Un grand merci à Nicolas de nous avoir fait découvrir son métier pendant quelques jours !
Découvre aussi